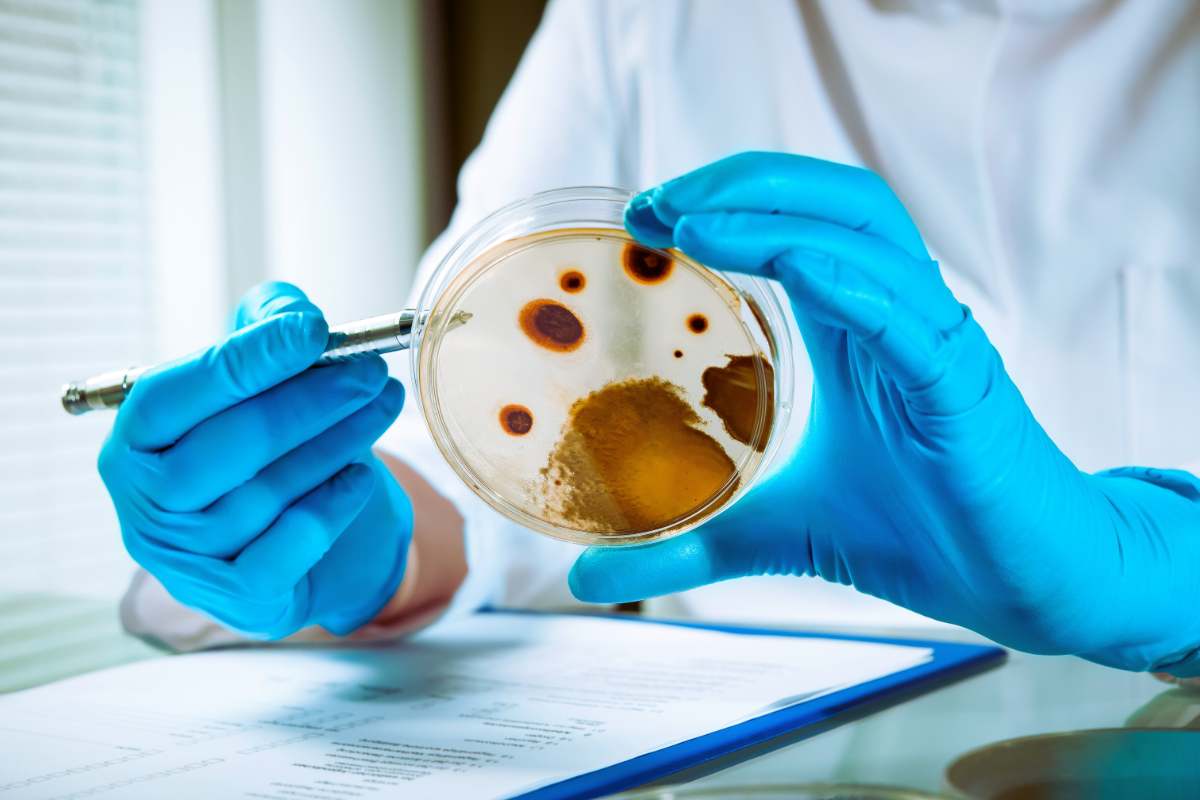

Non ci crederai: questo oggetto quotidiano è un ricettacolo di germi (e non è il wc!)
Forse non lo sai, ma questo oggetto che sei solito usare contiene parecchi germi. Ecco perché e come pulirlo al meglio
Siamo soliti avere questo oggetto e usarlo di frequente, soprattutto se si tratta di lavoro o piacere. Quello di cui però non sospettiamo minimamente è che potrebbe avere anche più germi di un WC, il che, in effetti potrebbe stupirci (ma in fondo neanche troppo).
Eppure, una ricerca portata avanti dalla compagnia assicurativa Insure and Go con la microbiologa Amy May Pointer, ha fatto emergere che quest’oggetto sarebbe 58 volte più sporco rispetto al WC presente in un bagno pubblico.
Ecco che cosa devi assolutamente sapere e farne tesoro, in modo da prenderti maggiore dell’oggetto in questione.
Quest’oggetto può contenere grandi quantità di germi: ecco come pulirlo alla perfezione
Se non hai idea che quest’oggetto possa essere tanto sporco, questa ricerca riuscirà a sorprenderti. Il suddetto studio, infatti, ha fatto emergere come le ruote delle valigie possano essere ben 58 volte più sporche, rispetto al WC pubblico.
Basta pensarci, e in effetti, le ruote si spostano in qualunque luogo, dagli aeroporti alle stazioni, ai marciapiedi. Spesso ci sostengono nel correre per prendere un treno, incappando anche in qualcosa di poco piacevole (ad esempio feci). Gli studiosi hanno analizzato le ruote di alcuni bagagli presenti in una stazione ferroviaria aeroportuale e hanno scovato microbi della pelle, muffe, batteri che in genere sono presenti in bagno, e germi che sono connessi a feci.
In linea generale, si tratta di batteri che possono essere causa di cattivi odori e le valigie potrebbero anche avere un effetto piuttosto appiccicoso. Le valigie, ovviamente, dobbiamo riportarle a casa e in certi casi, le si poggia sui letti, talvolta anche sui divani.
Non sarebbe proprio il massimo, dunque. Per questa ragione, ogni volta che si decide di partire per una destinazione, una volta rientrati, è importante disinfettare per bene le ruote dei bagagli. In linea generale, per un’accurata pulizia delle valigie e per rimuovere i batteri, si possono utilizzare delle pratiche salviette alcoliche.
Per ciò che concerne, invece, le ruote, si possono usare dei copri valigia che hanno anche funzione lavabile. «Potrebbe sembrare sciocco, ma coprire quelle ruote può impedire loro di diffondere batteri su tappeti o biancheria da letto. Potresti proteggere le tue lenzuola dal tipo di microbi che includono batteri irritanti per la pelle come le specie di Stafilococco», spiega la microbiologa.
È quindi importante tenere alla propria salute e quella di chi ci è attorno, pulendo bene i bagagli, ogni volta che si fa ritorno da un viaggio.
L'articolo Non ci crederai: questo oggetto quotidiano è un ricettacolo di germi (e non è il wc!) proviene da Blitz quotidiano.
Qual è la tua reazione?






